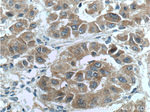
NRF2/NFE2L2 Antibody in Immunohistochemistry (Paraffin) (IHC (P))
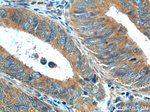
NRF2/NFE2L2 Antibody in Immunohistochemistry (Paraffin) (IHC (P))
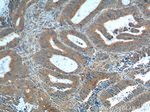
NRF2/NFE2L2 Antibody in Immunohistochemistry (Paraffin) (IHC (P))

Search
Proteintech
NRF2/NFE2L2 Polyclonal Antibody
{{$productOrderCtrl.translations['antibody.pdp.commerceCard.promotion.promotions']}}
{{$productOrderCtrl.translations['antibody.pdp.commerceCard.promotion.viewpromo']}}
{{$productOrderCtrl.translations['antibody.pdp.commerceCard.promotion.promocode']}}: {{promo.promoCode}} {{promo.promoTitle}} {{promo.promoDescription}}. {{$productOrderCtrl.translations['antibody.pdp.commerceCard.promotion.learnmore']}}
产品信息
16396-1-AP
种属反应
已发表种属
宿主/亚型
分类
类型
抗原
偶联物
形式
浓度
规格
纯化类型
保存液
内含物
保存条件
运输条件
产品详细信息
Immunogen sequence: SILSTEDPN QLTVNSLNSD ATVNTDFGDE FYSAFIAEPS ISNSMPSPAT LSHSLSELLN GPIDVSDLSL CKAFNQNHPE STAEFNDSDS GISLNTSPSV ASPEHSVESS SYGDTLLGLS DSEVEELDSA PGSVKQNGPK TPVHSSGDMV QPLSPSQGQS THVHDAQCEN TPEKELPVSP GHRKTPFTKD KHSSRLEAHL TRDELRAKAL HIPFPVEKII NLPVVDFNEM MSKEQFNEAQ LALIRDIRRR GKNKVAAQNC RKRKLENIVE LEQDLDHLKD EKEKLLKEKG ENDKSLHLLK KQLSTLYLEV FSMLRDEDGK PYSPSEYSLQ QTRDGNVFLV PKSKKPDVKK N (256-605 aa encoded by BC011558)
靶标信息
Nfr1 (also designated TCF11), Nrf2 and Nfr3 are bZIP transcription factors that heterodimer with Maf proteins to bind MARE (Maf recognition elements) sequences. Nrf2 is widely expressed and is thought to translocate to the nucleus after treatment with xenobiotics and antioxidants, which stimulate its release from a repressor protein Keap1.
仅用于科研。不用于诊断过程。未经明确授权不得转售。
生物信息学
蛋白别名: E4TF1-60; E4TF1A; NF-E2-like basic leucine zipper transcriptional activator; NF-E2-related factor 2; NFE2-related factor 2; NFT2; NRF2; NRF2A; nuclear factor erythroid 2-like 2; Nuclear factor erythroid 2-related factor 2; nuclear factor erythroid-derived 2-like 2; nuclear factor, erythroid 2 like 2; Nuclear factor, erythroid derived 2, like 2; unnamed protein product
基因别名: AI194320; HEBP1; IMDDHH; NFE2L2; Nrf-2; NRF2
UniProt ID: (Human) Q16236, (Mouse) Q60795, (Rat) O54968
Entrez Gene ID: (Human) 4780, (Mouse) 18024, (Rat) 83619